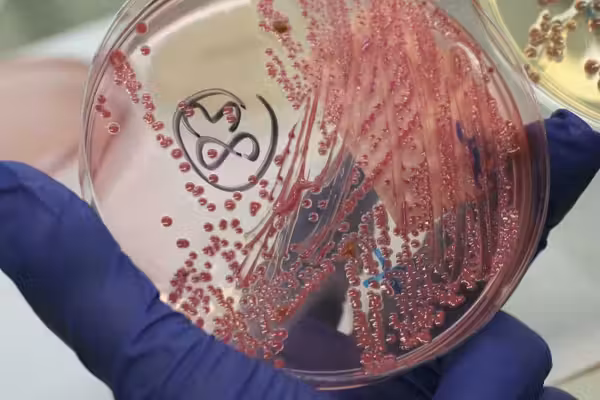
Another Chinese researcher busted for allegedly smuggling crop-harming biomaterial into America

© 2025 Blaze Media LLC. All rights reserved.
RECENT COLUMNS
Down the tubes: Flailing Oscars leaving ABC, moving online
https://www.theblaze.com/media-library/eyJhbGciOiJIUzI1NiIsInR5cCI6IkpXVCJ9.eyJpbWFnZSI6Imh0dHBzOi8vYXNzZXRzLnJibC5tcy81MzY4MjQzMy9vcmlnaW4uZ2lmIiwiZXhwaXJlc19hdCI6MTc1NDM1OTIwMH0.IodbT3VPX1zLKepZrrxQ_asoJiic1XCxtTuLeHyPxdE/image.gif
This is what ‘abolish America’ looks like in practice
https://assets.rbl.ms/47869171/origin.gif
How anti-fascism became the West’s civil religion
https://assets.rbl.ms/46941655/origin.gif
How unionizing hurt VW (it has nothing to do with wages)
https://www.theblaze.com/media-library/eyJhbGciOiJIUzI1NiIsInR5cCI6IkpXVCJ9.eyJpbWFnZSI6Imh0dHBzOi8vYXNzZXRzLnJibC5tcy81MzY4MjQ0Ny9vcmlnaW4uZ2lmIiwiZXhwaXJlc19hdCI6MTc2NzEyNTEyN30.NlGKuHsho29O2BARKQv6ISyQEwnsFrspoNl4OzK0rJc/image.gif
Conservatives face a choice in ’26: realignment or extinction
https://assets.rbl.ms/47868838/origin.gif
Sign up for the Blaze newsletter
By signing up, you agree to our Privacy Policy and Terms of Use, and agree to receive content that may sometimes include advertisements. You may opt out at any time.
ALL STORIES
Load More
© 2025 Blaze Media LLC. All rights reserved.
Get the stories that matter most delivered directly to your inbox.
By signing up, you agree to our Privacy Policy and Terms of Use, and agree to receive content that may sometimes include advertisements. You may opt out at any time.